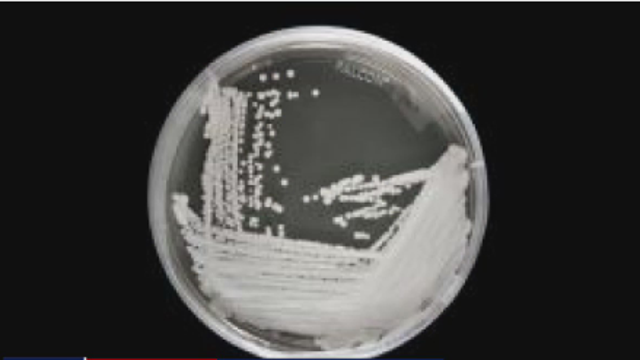
CDC: Untreatable 'superbug' outbreak discovered at DC nursing home

Tokyo Olympics: At least 100 US athletes are unvaccinated
About 100 of the U.S. athletes descending on Tokyo for the Olympics are unvaccinated, the U.S. Olympic and Paralympic Committee's medical chief said hours before Friday night's opening ceremony.
About 100 of the U.S. athletes descending on Tokyo for the Olympics are unvaccinated, the U.S. Olympic and Paralympic Committee's medical chief said hours before Friday night's opening ceremony.
DC Public Schools requiring face mask, covering for all students, staff
DC Public Schools are requiring all students, staff and visitors to wear a face mask or covering for the 2021-22 school year in addition to implementing other health and safety measures.
DC Public Schools are requiring all students, staff and visitors to wear a face mask or covering for the 2021-22 school year in addition to implementing other health and safety measures.
CDC: Untreatable 'superbug' outbreak discovered at DC nursing home
The CDC is reporting that a potentially dangerous and untreatable 'superbug' has been found at a DC area nursing home.
The CDC is reporting that a potentially dangerous and untreatable 'superbug' has been found at a DC area nursing home.
Concerns over Delta variant rise as more unvaccinated people contract COVID
D.C. Health reported four deaths and 200 confirmed ‘break-through’ cases as Delta variant concerns rise.
D.C. Health reported four deaths and 200 confirmed ‘break-through’ cases as Delta variant concerns rise.
DeSantis says there will be no mask mandates in Florida schools
"There's been talk about potentially people advocating at the federal level imposing compulsory masks on kids. We're not doing that in Florida, OK?" DeSantis said. "We need our kids to breathe."
"There's been talk about potentially people advocating at the federal level imposing compulsory masks on kids. We're not doing that in Florida, OK?" DeSantis said. "We need our kids to breathe."
Pfizer vaccine 88% effective against delta variant, study finds
A new study published in the New England Journal of Medicine found that the Pfizer vaccine after two doses was 88% effective against symptomatic illness from the delta variant.
A new study published in the New England Journal of Medicine found that the Pfizer vaccine after two doses was 88% effective against symptomatic illness from the delta variant.
Death rates surge in Southeast Asia as COVID-19 spreads
A record number of new cases being reported in countries across the region have left health care systems struggling and governments scrambling to implement new restrictions to try to slow the spread.
A record number of new cases being reported in countries across the region have left health care systems struggling and governments scrambling to implement new restrictions to try to slow the spread.
IRS stimulus checks: Petition for additional $2,000 monthly payments nears 3 million
A Change.org petition calling on Congress to send additional $2,000 monthly economic stimulus checks to U.S. families is nearing its goal of three million signatures.
A Change.org petition calling on Congress to send additional $2,000 monthly economic stimulus checks to U.S. families is nearing its goal of three million signatures.
CDC: 'No intention of changing' mask guidance 'at this time'
The CDC has “no intention” of changing its masking guidance, even as unvaccinated Americans drive a new surge of COVID-19.
The CDC has “no intention” of changing its masking guidance, even as unvaccinated Americans drive a new surge of COVID-19.
Questions about the COVID-19 Delta variant? Health expert has answers
FOX 5 sought out Dr. Amesh Adalja, senior scholar at the Johns Hopkins Bloomberg School of Public Health’s Center for Health Security to answer common questions about the delta variant of COVID-19.
FOX 5 sought out Dr. Amesh Adalja, senior scholar at the Johns Hopkins Bloomberg School of Public Health’s Center for Health Security to answer common questions about the delta variant of COVID-19.
China rejects WHO's terms for further study of COVID-19 origins
A senior Chinese health official said he was “taken aback" that the WHO plan includes further investigation of the COVID-19 lab leak theory.
A senior Chinese health official said he was “taken aback" that the WHO plan includes further investigation of the COVID-19 lab leak theory.
New COVID-19 safety guidelines, mask mandates for students in VA: Here's what it means for your child
School districts now have new guidelines for the new school year.
School districts now have new guidelines for the new school year.
Nurse shortage one of many contributing factors to long ER wait times in DC area
Nurse shortages have impacted hospitals across the U.S., even prior to COVID-19.
Nurse shortages have impacted hospitals across the U.S., even prior to COVID-19.
Virginia officials release updated COVID-19 safety guidelines, mask mandate for schools
The Virginia Department of Health and the Virginia Department of Education released new guidance Wednesday for PreK-12 schools for the upcoming 2021-2022 school year which includes supporting school divisions in making decisions on masking and other prevention measures.
The Virginia Department of Health and the Virginia Department of Education released new guidance Wednesday for PreK-12 schools for the upcoming 2021-2022 school year which includes supporting school divisions in making decisions on masking and other prevention measures.
Pfizer vaccine will be made at South African firm, a first for Africa
This is the first time Pfizer's vaccine will be produced in Africa, in a move to help address the continent's desperate need for more doses amid a recent surge of cases.
This is the first time Pfizer's vaccine will be produced in Africa, in a move to help address the continent's desperate need for more doses amid a recent surge of cases.
4 companies on verge of settling $26B deal in lawsuits over toll of opioid prescriptions
The three biggest U.S. drug distribution companies and the drugmaker Johnson & Johnson are on the verge of a $26 billion deal to settle lawsuits brought by state and local governments across the country over the toll of prescription opioids.
The three biggest U.S. drug distribution companies and the drugmaker Johnson & Johnson are on the verge of a $26 billion deal to settle lawsuits brought by state and local governments across the country over the toll of prescription opioids.
More than 1.5M children lost at least 1 caregiver from a death related to COVID-19 last year
A recent study funded by the National Institutes of Health estimated that 1.5 million around the globe lost at least one caregiver to a death related to COVID-19 in the first 14 months of the pandemic.
A recent study funded by the National Institutes of Health estimated that 1.5 million around the globe lost at least one caregiver to a death related to COVID-19 in the first 14 months of the pandemic.
Study: Screen time linked to cognitive issues in children born preterm
School-age children who were born extremely preterm and engage in more than two hours of screen time per day are more likely to experience cognitive and behavioral problems, according to an NIH study.
School-age children who were born extremely preterm and engage in more than two hours of screen time per day are more likely to experience cognitive and behavioral problems, according to an NIH study.
Study: J&J COVID-19 vaccine significantly less effective against delta variant
Study authors found that while the two-dose vaccines were 94-95% effective in preventing COVID-19 from the delta and lambda variants, the Johnson & Johnson vaccine had only 66.9% efficacy “in preventing moderate to severe disease.”
Study authors found that while the two-dose vaccines were 94-95% effective in preventing COVID-19 from the delta and lambda variants, the Johnson & Johnson vaccine had only 66.9% efficacy “in preventing moderate to severe disease.”
Judge rules Indiana University can mandate COVID-19 vaccine for students, staff
In a ruling dated Sunday, U.S. District Judge Damon Leichty in South Bend rejected a request from eight IU students who sought to block the requirement.
In a ruling dated Sunday, U.S. District Judge Damon Leichty in South Bend rejected a request from eight IU students who sought to block the requirement.